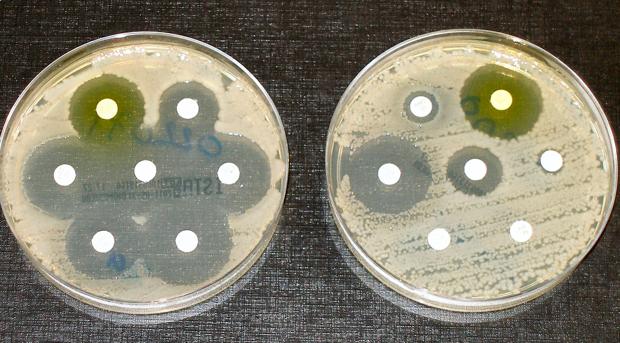

Las bacterias se pueden ayudar entre ellas para tolerar mejor los antibióticos
Un nuevo trabajo del Laboratorio de Dinámica de Sistemas Biológicos de la Universidad Pompeu Fabra de Barcelona muestra que la respuesta de las bacterias a los antibióticos puede depender de otras especies de bacterias con las que conviven, de forma que unas pueden hacer a otras más tolerantes a los antibióticos. El estudio, que se publica hoy en la revista Science Advances, puede afectar al tratamiento de infecciones bacterianas, ya que sugiere nuevas estrategias para luchar contra estos patógenos. El equipo ha estudiado cómo las comunidades con múltiples especies de bacterias responden conjuntamente a los antibióticos Desde el descubrimiento de la penicilina hace casi 90 años, los antibióticos han salvado millones de vidas. Actualmente, se conoce con detalle la concentración de cada antibiótico necesaria para eliminar una gran variedad de especies de bacterias. Estos análisis se hacen habitualmente en cultivos donde cada especie de bacteria vive por sí sola. No obstante, a menudo en las infecciones no encontramos una única especie de bacteria, sino que conviven múltiples de ellas que pueden interaccionar, compartiendo todo tipo de señales químicas. Además, nuestro cuerpo contiene una gran cantidad de bacterias beneficiosas (la microbiota), con las que los patógenos pueden convivir también. Por eso, en este estudio, los investigadores han planteado cómo las comunidades con múltiples especies de bacterias responden conjuntamente a los antibióticos, indican los autores. Revelan que cuando dos especies concretas de bacterias conviven, su respuesta a un antibiótico es opuesta a cuando están solas Para abordar esta pregunta, el equipo ha estudiado cómo las bacterias Bacillus subtilis y Escherichia coli respondían al antibiótico ampicilina. En solitario, E. coli es sensible a este antibiótico –a partir de una determinada concentración no puede crecer– y B. subtilis es tolerante y consigue crecer. Letícia Galera-Laporta, primera autora del estudio, explica que «de forma contraintuitiva, observamos que cuando las dos especies de bacterias conviven, su respuesta al antibiótico es opuesta a cuando están solas. La bacteria que podía sobrevivir muere y al revés». Modelo matématico Con la ayuda de un modelo matemático pudieron ver que lo que varía es su respuesta colectiva, como resultado del cambio en la disponibilidad del medicamento para cada especie de bacteria en presencia de la otra. La ampicilina inactiva a unas proteínas necesarias para que las bacterias fabriquen su pared celular, y así impide que estas puedan crecer. Bacillus subtilis es tolerante a este antibiótico porque lo inactiva y reduce la cantidad libre en el medio. Esto beneficia a E. coli cuando ambas especies conviven, porque hace que la cantidad de ampicilina no llegue al umbral necesario para matarla. En cambio, E. coli no es capaz por sí misma de inactivar al antibiótico, sino que se comporta como una esponja. Durante un rato retiene el antibiótico y después lo devuelve al medio. Esta función de buffer retrasa la supresión del antibiótico en el medio, y por tanto perjudica a B. subtilis, ya que hace que quede antibiótico en el ambiente durante un periodo en el cual B. subtilis ya lo habría eliminado si estuviera sola. Mecanismos no genéticos de la resistencia La mayoría de estudios de este tipo se centran en la resistencia genética a los antibióticos mediante mutaciones, que es un aspecto muy importante. «Pero con estudios como estos queremos mostrar la importancia de no perder de vista que la supervivencia de las bacterias a los antibióticos se puede dar por otros mecanismos no genéticos», explica Jordi Garcia-Ojalvo, catedrático de Biología de Sistemas de la UPF que también participa en el estudio. Los resultados indican que habría que considerar el contexto de las bacterias para elegir la dosis de antibiótico adecuada. Los mecanismos que se muestran en este trabajo no son específicos de las dos especies de bacterias y del antibiótico que se han utilizado. Este hallazgo dificulta la elección de la dosis de antibióticos en el tratamiento de infecciones bacterianas, porque la información disponible hace referencia a las especies cuando se encuentran de forma aislada. Por otro lado, el estudio apunta también a la posibilidad de utilizar bacterias no patogénicas para sensibilizar a otras que sí que lo son. En definitiva, «hay que considerar el contexto microbiano en el que se encuentran las bacterias, para poder mejorar la información que permita escoger la dosis adecuada de antibiótico en cada caso», concluye García-Ojalvo.
Un nuevo trabajo del Laboratorio de Dinámica de Sistemas Biológicos de la Universidad Pompeu Fabra de Barcelona muestra que la respuesta de las bacterias a los antibióticos puede depender de otras especies de bacterias con las que conviven, de forma que unas pueden hacer a otras más tolerantes a los antibióticos. El estudio, que se publica hoy en la revista Science Advances, puede afectar al tratamiento de infecciones bacterianas, ya que sugiere nuevas estrategias para luchar contra estos patógenos. El equipo ha estudiado cómo las comunidades con múltiples especies de bacterias responden conjuntamente a los antibióticos Desde el descubrimiento de la penicilina hace casi 90 años, los antibióticos han salvado millones de vidas. Actualmente, se conoce con detalle la concentración de cada antibiótico necesaria para eliminar una gran variedad de especies de bacterias. Estos análisis se hacen habitualmente en cultivos donde cada especie de bacteria vive por sí sola. No obstante, a menudo en las infecciones no encontramos una única especie de bacteria, sino que conviven múltiples de ellas que pueden interaccionar, compartiendo todo tipo de señales químicas. Además, nuestro cuerpo contiene una gran cantidad de bacterias beneficiosas (la microbiota), con las que los patógenos pueden convivir también. Por eso, en este estudio, los investigadores han planteado cómo las comunidades con múltiples especies de bacterias responden conjuntamente a los antibióticos, indican los autores. Revelan que cuando dos especies concretas de bacterias conviven, su respuesta a un antibiótico es opuesta a cuando están solas Para abordar esta pregunta, el equipo ha estudiado cómo las bacterias Bacillus subtilis y Escherichia coli respondían al antibiótico ampicilina. En solitario, E. coli es sensible a este antibiótico –a partir de una determinada concentración no puede crecer– y B. subtilis es tolerante y consigue crecer. Letícia Galera-Laporta, primera autora del estudio, explica que «de forma contraintuitiva, observamos que cuando las dos especies de bacterias conviven, su respuesta al antibiótico es opuesta a cuando están solas. La bacteria que podía sobrevivir muere y al revés». Modelo matématico Con la ayuda de un modelo matemático pudieron ver que lo que varía es su respuesta colectiva, como resultado del cambio en la disponibilidad del medicamento para cada especie de bacteria en presencia de la otra. La ampicilina inactiva a unas proteínas necesarias para que las bacterias fabriquen su pared celular, y así impide que estas puedan crecer. Bacillus subtilis es tolerante a este antibiótico porque lo inactiva y reduce la cantidad libre en el medio. Esto beneficia a E. coli cuando ambas especies conviven, porque hace que la cantidad de ampicilina no llegue al umbral necesario para matarla. En cambio, E. coli no es capaz por sí misma de inactivar al antibiótico, sino que se comporta como una esponja. Durante un rato retiene el antibiótico y después lo devuelve al medio. Esta función de buffer retrasa la supresión del antibiótico en el medio, y por tanto perjudica a B. subtilis, ya que hace que quede antibiótico en el ambiente durante un periodo en el cual B. subtilis ya lo habría eliminado si estuviera sola. Mecanismos no genéticos de la resistencia La mayoría de estudios de este tipo se centran en la resistencia genética a los antibióticos mediante mutaciones, que es un aspecto muy importante. «Pero con estudios como estos queremos mostrar la importancia de no perder de vista que la supervivencia de las bacterias a los antibióticos se puede dar por otros mecanismos no genéticos», explica Jordi Garcia-Ojalvo, catedrático de Biología de Sistemas de la UPF que también participa en el estudio. Los resultados indican que habría que considerar el contexto de las bacterias para elegir la dosis de antibiótico adecuada. Los mecanismos que se muestran en este trabajo no son específicos de las dos especies de bacterias y del antibiótico que se han utilizado. Este hallazgo dificulta la elección de la dosis de antibióticos en el tratamiento de infecciones bacterianas, porque la información disponible hace referencia a las especies cuando se encuentran de forma aislada. Por otro lado, el estudio apunta también a la posibilidad de utilizar bacterias no patogénicas para sensibilizar a otras que sí que lo son. En definitiva, «hay que considerar el contexto microbiano en el que se encuentran las bacterias, para poder mejorar la información que permita escoger la dosis adecuada de antibiótico en cada caso», concluye García-Ojalvo.Fuente Salud https://ift.tt/2IkuMjJ
via abc.es




No hay comentarios
Publicar un comentario